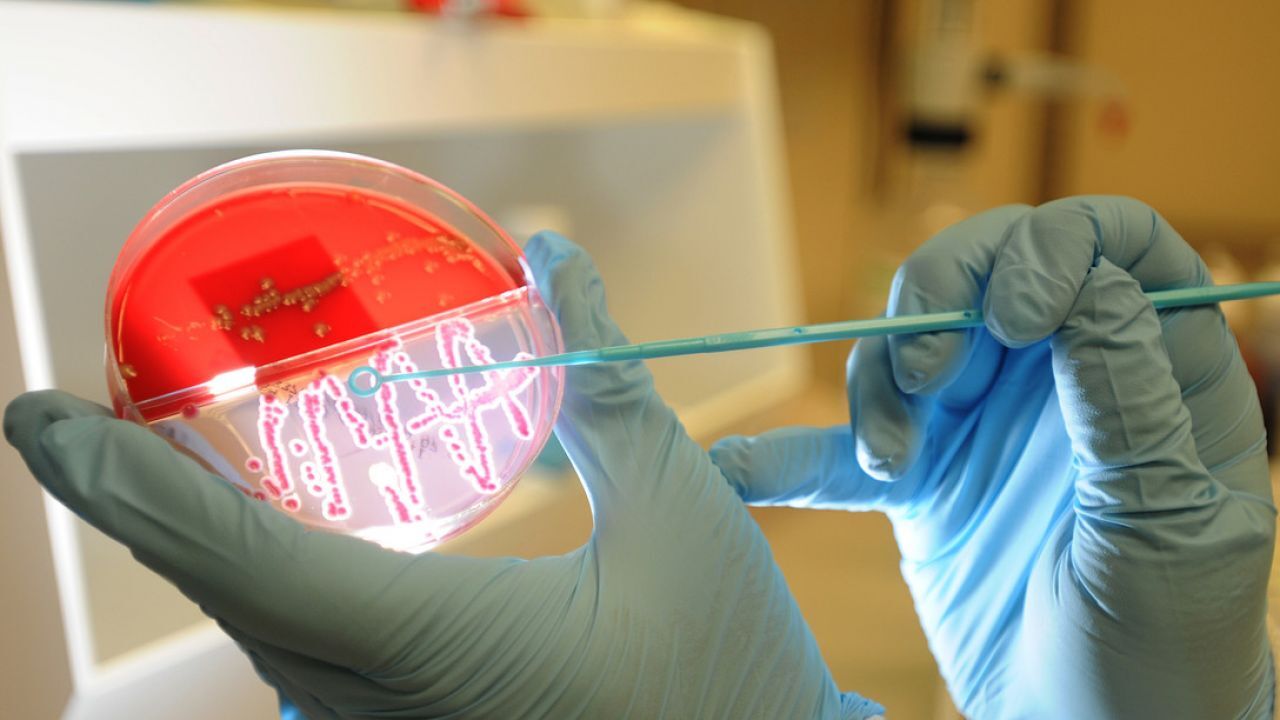

تحليل مزرعة الدم
يتمّ إجراء تحليل مزرعة الدم ( Blood Culture) لِمعرفة نوع البكتيريا أو الفطريّات المسبّبة لعدوى الدم، وغالباً ما تنتقل العدوى للدم نتيجة الإصابة بأحد أنواع العدوى الخطيرة في أجزاء أخرى من الجسم، وتجدر الإشارة إلى أنّ عدوى الدم قد تؤدي إلى عدد من المضاعفات الصحيّة الخطيرة مثل التهاب السحايا (بالإنجليزية: Meningitis)، والتهاب العظم والنقيّ (بالإنجليزية: Osteomyelitis)، وتسمُّم الدَّم (بالإنجليزية: Sepsis)، والتهاب شغاف القلب (بالإنجليزية: Endocarditis)، ومن الجدير بالذكر عدم الحاجة إلى اتخاذ أيّ من الإجراءات الخاصة قبل القيام بالتحليل، ولكن يجدر إعلام الطبيب في حال استخدام أحد أنواع المضادّات الحيويّة (بالإنجليزية: Antibiotics) مؤخراً.
دواعي إجراء تحليل مزرعة الدم
قد يقوم الطبيب بطلب إجراء تحليل مزرعة الدَّم في حال ملاحظة ظهور أي من الأعراض التي قد تدلّ على وجود عدوى في الدم، وتساعد نتائج التحليل الطبيب على تحديد العلاج المناسب للحالة، ومن الأعراض التي قد تستدعي إجراء التحليل ما يلي:
- الحمّى، والقشعريرة.
- التعب والإعياء.
- الغثيان، والتشوّش.
- حدوث نقص في عدد مرات التبوُّل.
- ارتفاع معدَّل ضربات القلب.
- الانخفاض الحادّ في ضغط الدَّم.
- التهاب عدّة مناطق مختلفة من الجسم.
- تشكّل الخثرات الدمويّة في الأوعية الدمويّة الصغيرة.
- فشل الأعضاء في الحالات الشديدة.
نتائج تحليل مزرعة الدم
يتمّ أخذ عينة دم من الشخص في أحد المراكز الطبيّة المختصة، وفي حال ظهور نتائج إيجابيّة يتمّ تحديد نوع البكتيريا أو الفطريّات المسبّبة للعدوى، كما قد يحتاج الطبيب إلى إجراء تحليل آخر لتحديد الدواء المناسب للقضاء على العدوى، وبسبب خطورة الإصابة بعدوى الدم يقوم الطبيب في العادة بالبدء في العلاج باستخدام أحد المضادّات الحيويّة واسعة الطيف (: Broad-spectrum antibiotics) إلى حين ظهور نتائج التحليل وتحديد العلاج المناسب للعدوى.